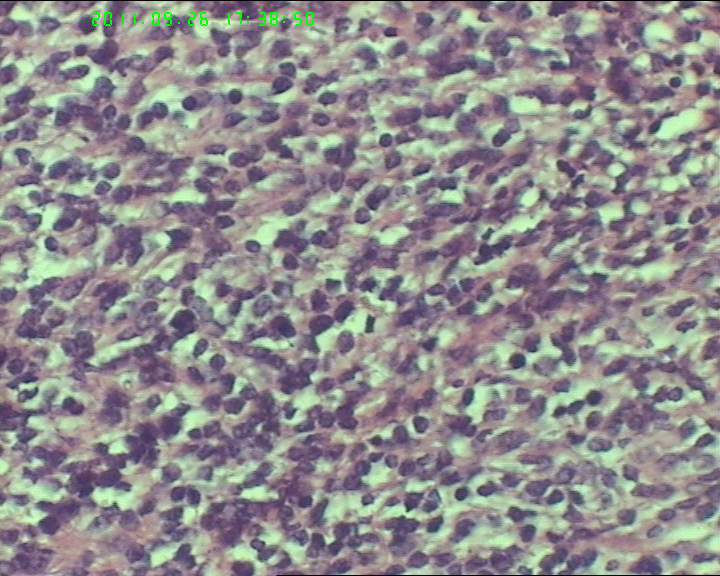
74岁女性盆腔包块，肉瘤？图9
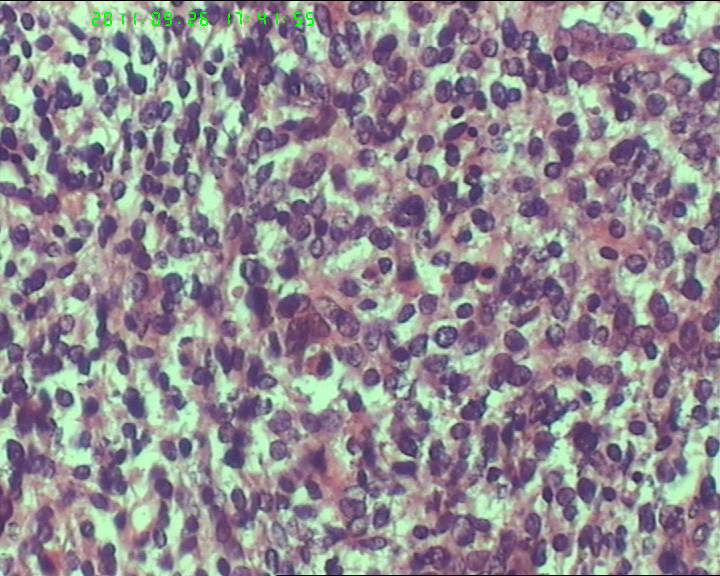
74岁女性盆腔包块，肉瘤？图23

| 图片: | |
|---|---|
| 名称: | |
| 描述: | |
- 74岁女性盆腔包块,肉瘤?
包块与大网膜粘连,根部附着于肠系膜,脾曲处有较多积血块 但无活动性出血,肠系膜上有较多粟粒样结节,白色质韧。与子宫 输卵管 卵巢没有关系.
灰白不整形肿物一个,大小18*15*9cm,表面结节状,包膜完整,切面灰白,中央可见坏死区,质软,范围5*4cm。其余切面多彩 部分半透明状 质中。

名称:图1
描述:20110926-23.jpg.jpg

名称:图2
描述:20110926-24.jpg.jpg

名称:图3
描述:20110926-26.jpg.jpg

名称:图4
描述:20110926-25.jpg.jpg

名称:图5
描述:20110926-28.jpg.jpg

名称:图6
描述:20110926-29.jpg.jpg

名称:图7
描述:20110926-30.jpg.jpg

名称:图8
描述:20110926-31.jpg.jpg
名称:图9
描述:20110926-32.jpg.jpg

名称:图10
描述:20110926-33.jpg.jpg

名称:图11
描述:20110926-34.jpg.jpg

名称:图12
描述:20110926-35.jpg.jpg

名称:图13
描述:20110926-36.jpg.jpg

名称:图14
描述:20110926-37.jpg.jpg

名称:图15
描述:20110926-38.jpg.jpg

名称:图16
描述:20110926-39.jpg.jpg

名称:图17
描述:20110926-40.jpg.jpg

名称:图18
描述:20110926-41.jpg.jpg

名称:图19
描述:20110926-42.jpg.jpg

名称:图20
描述:20110926-43.jpg.jpg

名称:图21
描述:20110926-44.jpg.jpg

名称:图22
描述:20110926-45.jpg.jpg
名称:图23
描述:20110926-46.jpg.jpg

名称:图24
描述:20110926-47.jpg.jpg
标签:
-
本帖最后由 samool 于 2011-09-27 09:06:38 编辑
×参考诊断
鉴别诊断排排队:1、GIST,2、MPNST,3、去分化脂肪肉瘤,4、恶性间皮瘤,5、恶性SFT,6、平肉
主要考虑前二者。CD34,CD117,S-100,BCL-2,SMA, D2-40,CR, VIM. 结果如何?请楼主揭谜底吧。

- If you have great talents, industry will improve them; if you have but moderate abilities, industry will supply their deficiency. 如果你很有天赋,勤勉会使其更加完美;如果你能力一般,勤勉会补足其缺陷。




















